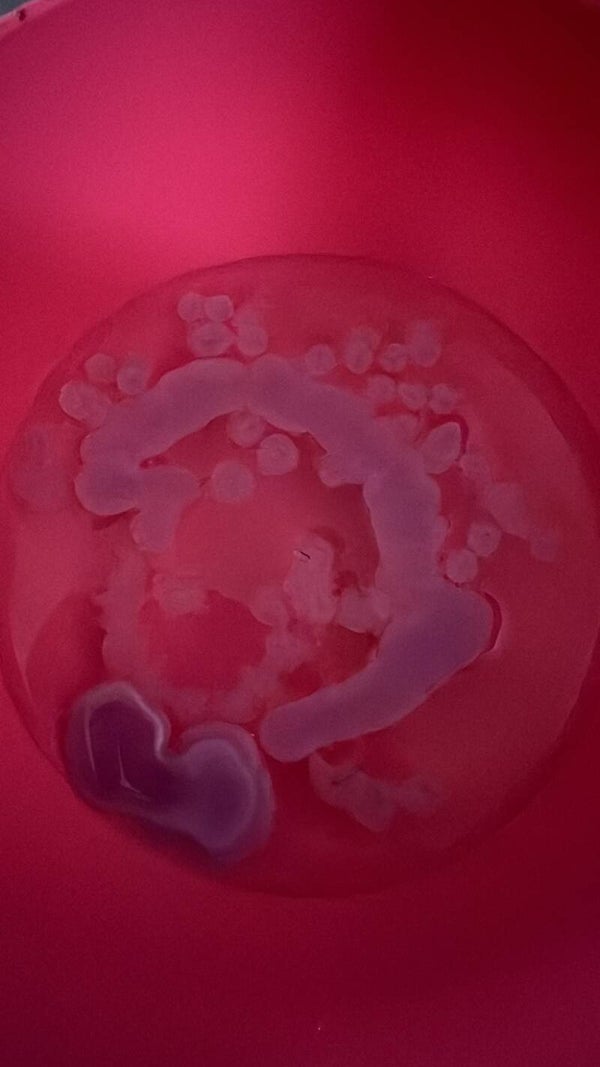

Wax Reading
£32.00
🕯️ Wax Reading 🕯️
Unlock hidden knowledge and gain snippets of insight into your life with a powerful Wax Reading.
During this reading, I will light a candle and allow the wax to drip into a bowl of water. From the shapes and patterns formed, I will interpret what I see, sense, and hear — bringing forward the guidance meant for you.
✨ Your reading will be performed with care and delivered directly to your email within 24 hours (depending on my traffic).